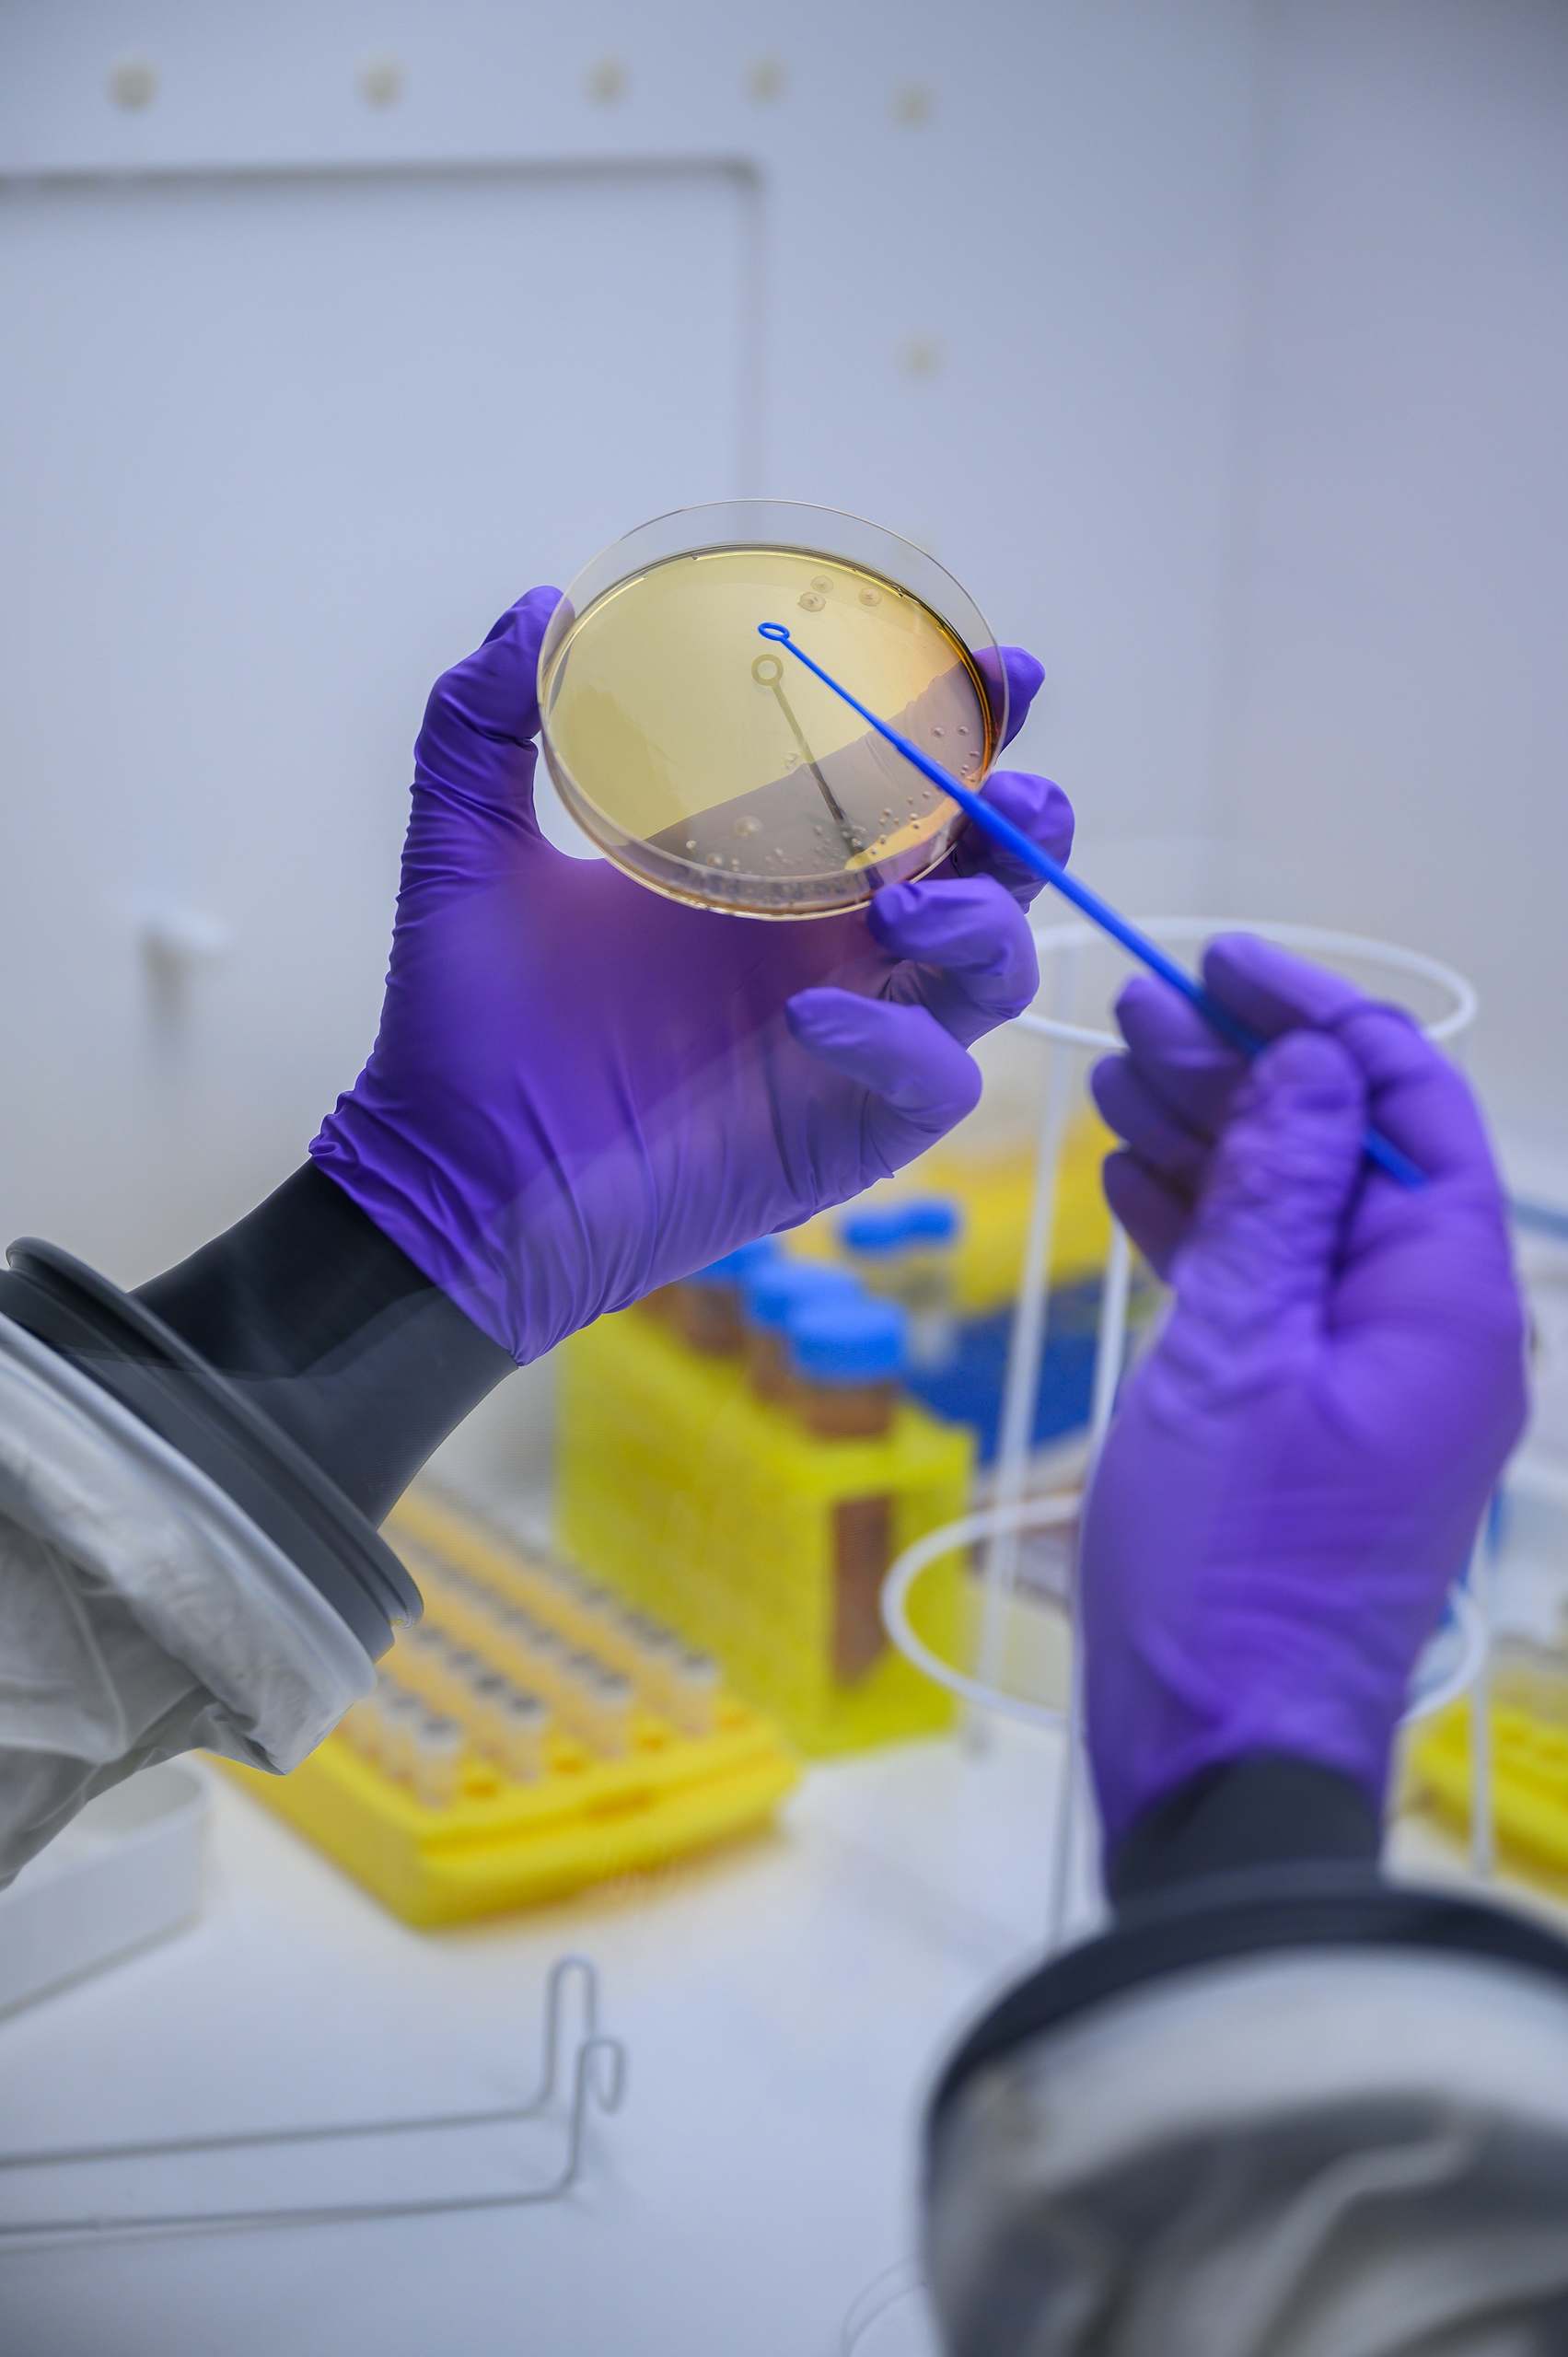

Des permanences téléphoniques :
AFSEP Des psychologues à votre écoute au 0 805 691 379. Nathanaël et…
Lancement officiel du projet STEP !
Le projet STEP. STEP pour dire STOP à la SEP (Sclérose En Plaques). Ce projet…
"Un dragon" témoigne : Vivre avec un père atteint de la Sclérose en Plaques
Présentation - Pseudonyme : Un dragon - j'ai 23 ans - Mon père a une SEP.…
Guillaume Lodini "Heaven’s Door : ascension du Kilimandjaro par un patient atteint d’une sclérose en plaques"
Documentaire « Heaven’s Door : ascension du Kilimandjaro par un patient atteint…
Bande dessinée Galapagos
Cette BD est un monument à ne pas manquer. L’auteur Michaël Olbrechts y raconte…
Vieillir avec la sclérose en plaques - live avec le Dr Ouallet
Live du mardi 5 novembre : « Vieillir avec une SEP ». En présence du Dr…
SP Canada : Démystifier la recherche clinique
Série Webinaires SP - Ce qu'en disent les experts. À l’occasion de ce…